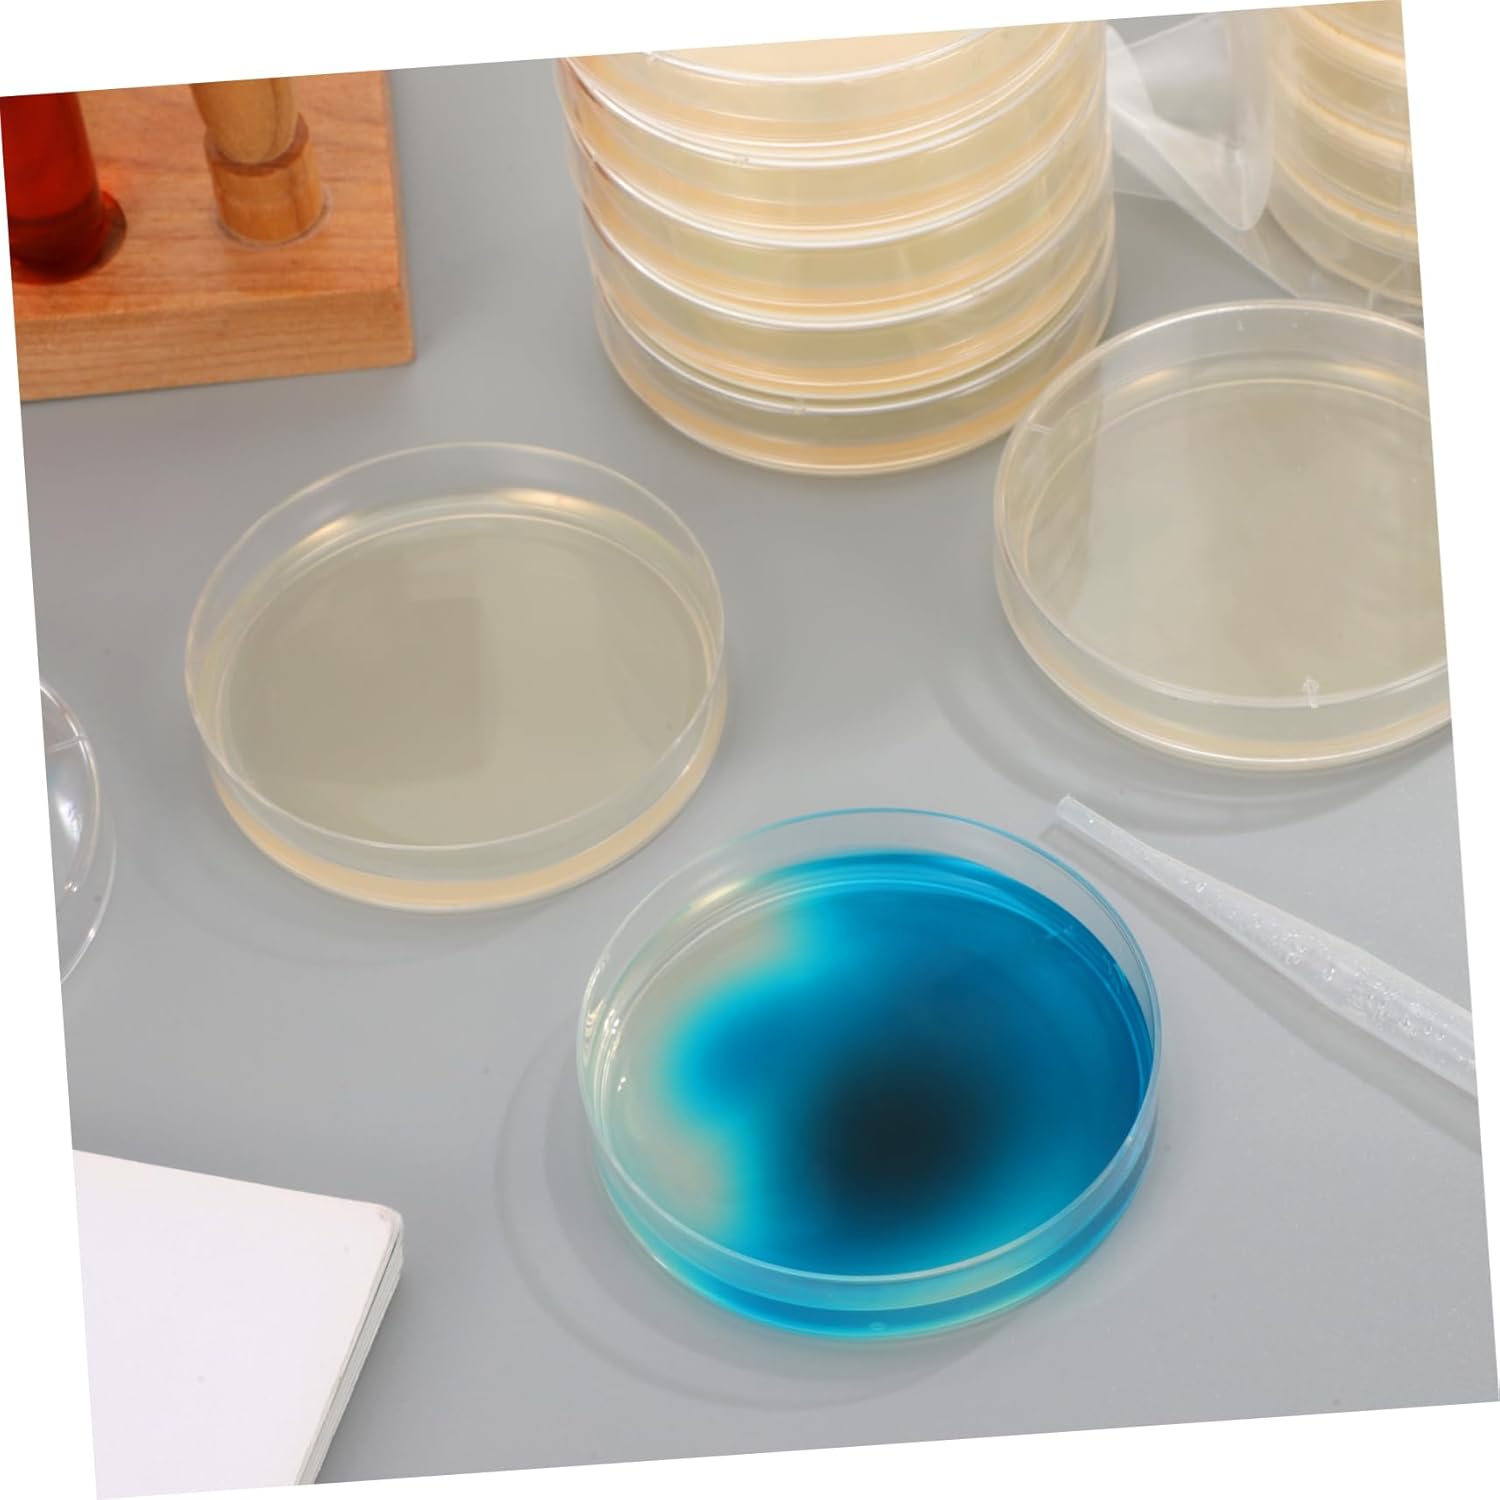

New
Arrivals/Restock
Ciieeo Pack of 20 Pre-Cast Agar Plates Petri Dishes 7.00 x 7.00 x 1.00 cm for Scientific Experiments and Laboratory Applications Nutrient Medium Plates for Microbiology and School Projects
 Limited Time Sale
Limited Time SaleUntil the end
15
15
08
$54.00 cheaper than the new price!!
Free shipping for purchases over $99 ( Details )
Free cash-on-delivery fees for purchases over $99
Free cash-on-delivery fees for purchases over $99
See all stores
Please note that the sales price and tax displayed may differ between online and in-store. Also, the product may be out of stock in-store.
New $90.00
Product details
| Management number | 211014133 | Release Date | 2026/04/04 | List Price | $36.00 | Model Number | 211014133 | ||
|---|---|---|---|---|---|---|---|---|---|
| Category | |||||||||
- HIGH QUALITY AGAR PLATES Precast Petri dishes with breeding ground provide a practical solution for scientific experiments and promote faster growth of crops in the laboratory environment
- Practical design and easy to use: the 7.00 x 7.00 x 1.00 cm agar plates are compact, easy to transport and ideal for use in school, research and laboratory purposes
- Safe and versatile: the pre-cast agar plates are made of food-safe material, provide safe use and are suitable for a wide range of scientific applications
- Extensive accessories for laboratory experiments: with 20 agar plates in the set, you will receive sufficient material for numerous experiments in the fields of microbiology, biology and other scientific studies
- Wide applications: the petri dishes with agar are ideal for science experimentation, student projects and research work, support the cultivation and storage of samples safely and efficiently
Correction of product information
If you notice any omissions or errors in the product information on this page, please use the correction request form below.
Correction Request Form